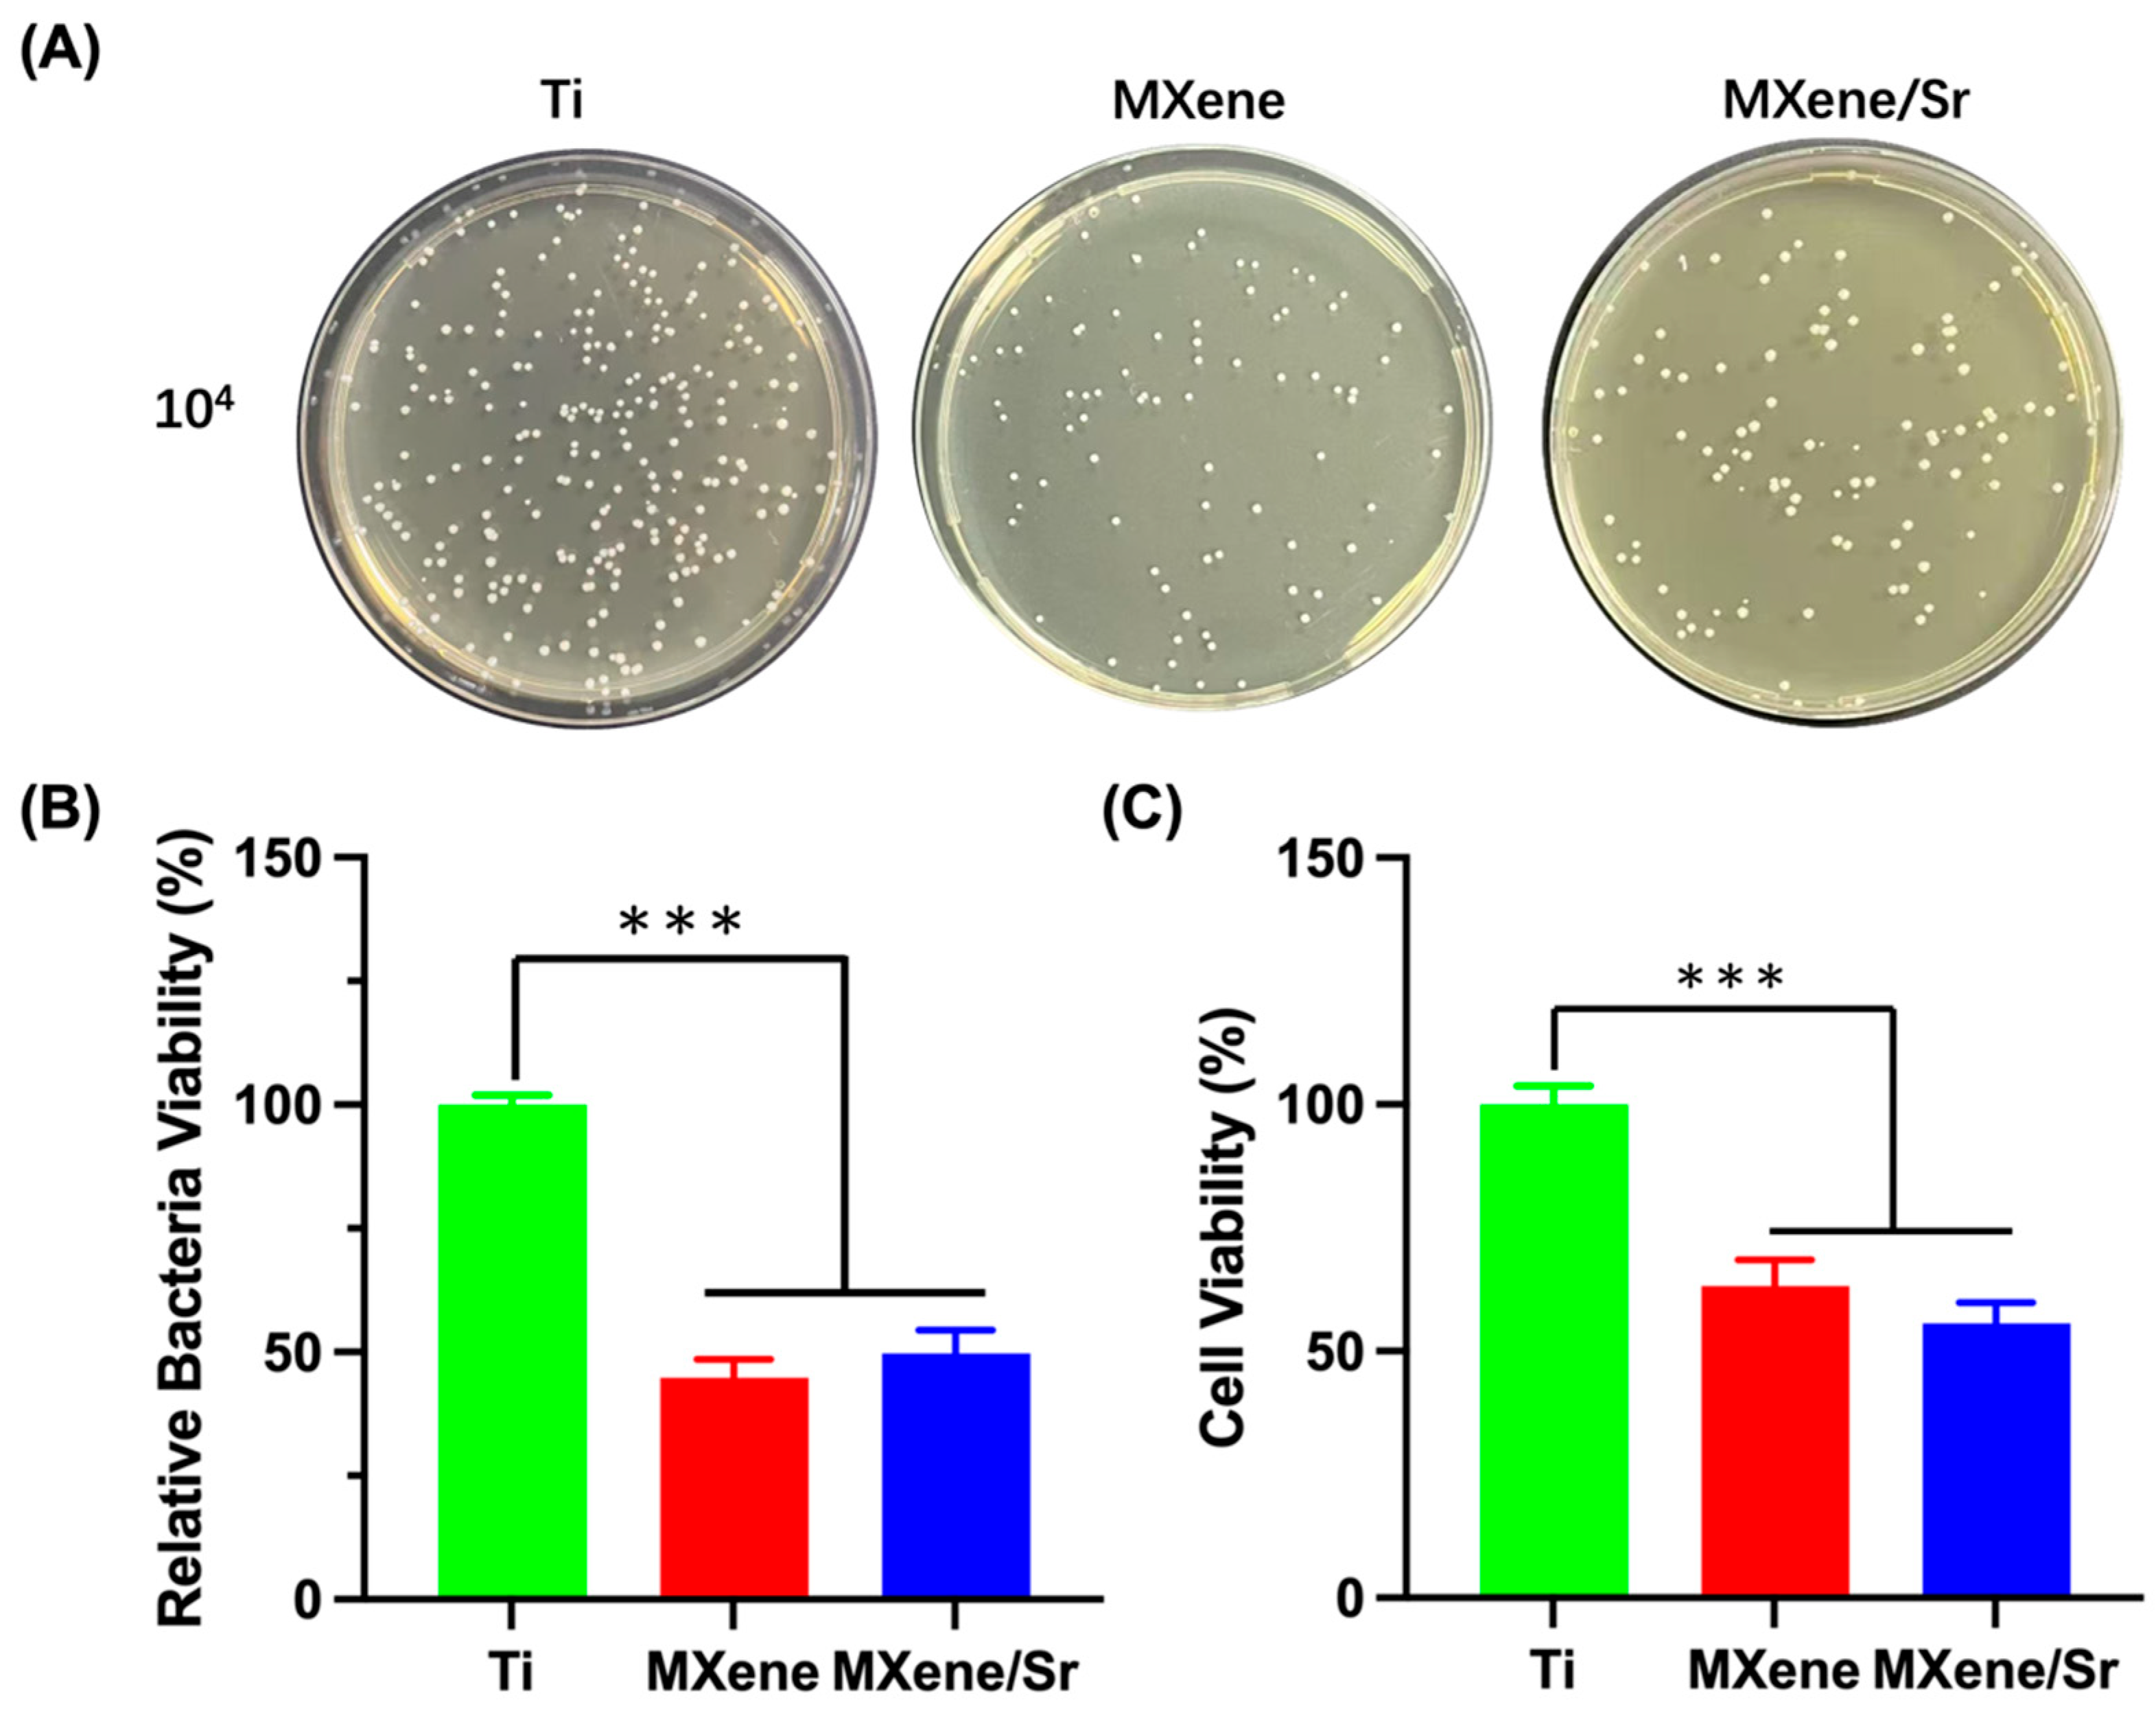
Coatings 15 00847 g010

Strontium-Doped Ti3C2Tx MXene Coatings on Titanium Surfaces: Synergistic Osteogenesis Enhancement and Antibacterial Activity Evaluation
Abstract
1. Introduction
2. Materials and Methods
2.1. Coating Preparation
2.2. Material Characterization
2.3. In Vitro Cell Compatibility Evaluation
2.3.1. Cell Culture
2.3.2. Cytotoxicity
2.3.3. Transwell Migration Assay
2.3.4. Cell Proliferation
2.4. In Vitro Osteogenic Differentiation Detection of Cells
2.4.1. ALP Staining
2.4.2. ARS Staining
2.5. In Vitro Antibacterial Test
2.5.1. Bacterial Culture
2.5.2. Live/Dead Bacterial Staining Observation
2.5.3. Bacterial Cell Integrity Observation
2.5.4. Agar Re-Culturing and Colony Counting
2.5.5. Bacterial Activity Quantification
2.6. Data Statistics and Analysis
3. Results and Discussion
3.1. Material Characterization
3.2. In Vitro Cell Biocompatibility Evaluation
3.2.1. Cytotoxicity and Proliferation
3.2.2. Transwell Migration Assay
3.3. In Vitro Osteogenic Differentiation of Cells
3.4. In Vitro Antibacterial Evaluation
3.4.1. Bacterial Integrity Analysis
3.4.2. Agar Culture and Quantitative Assessment of Bacterial Viability
4. Conclusions
Author Contributions
Funding
Institutional Review Board Statement
Informed Consent Statement
Data Availability Statement
Acknowledgments
Conflicts of Interest
References
- Lu, X.; Wu, Z.; Xu, K.; Wang, X.; Wang, S.; Qiu, H.; Li, X.; Chen, J. Multifunctional Coatings of Titanium Implants Toward Promoting Osseointegration and Preventing Infection: Recent Developments. Front. Bioeng. Biotechnol. 2021, 9, 783816. [Google Scholar] [CrossRef] [PubMed]
- Zhu, G.; Wang, G.; Li, J.J. Advances in implant surface modifications to improve osseointegration. Mater. Adv. 2021, 2, 6901–6927. [Google Scholar] [CrossRef]
- Abu Alfaraj, T.; Al-Madani, S.; Alqahtani, N.S.; Almohammadi, A.A.; Alqahtani, A.M.; AlQabbani, H.S.; Bajunaid, M.K.; A Alharthy, B.; Aljalfan, N. Optimizing Osseointegration in Dental Implantology: A Cross-Disciplinary Review of Current and Emerging Strategies. Cureus 2023, 15, e47943. [Google Scholar] [CrossRef] [PubMed]
- Mandracci, P.; Mussano, F.; Rivolo, P.; Carossa, S. Surface Treatments and Functional Coatings for Biocompatibility Improvement and Bacterial Adhesion Reduction in Dental Implantology. Coatings 2016, 6, 7. [Google Scholar] [CrossRef]
- Alves, C.H.; Russi, K.L.; Rocha, N.C.; Bastos, F.; Darrieux, M.; Parisotto, T.M.; Girardello, R. Host-microbiome interactions regarding peri-implantitis and dental implant loss. J. Transl. Med. 2022, 20, 425. [Google Scholar] [CrossRef] [PubMed]
- Dong, H.; Liu, H.; Zhou, N.; Li, Q.; Yang, G.; Chen, L.; Mou, Y. Surface Modified Techniques and Emerging Functional Coating of Dental Implants. Coatings 2020, 10, 1012. [Google Scholar] [CrossRef]
- Kumaravel, V.; Nair, K.M.; Mathew, S.; Bartlett, J.; Kennedy, J.E.; Manning, H.G.; Whelan, B.J.; Leyland, N.S.; Pillai, S.C. Antimicrobial TiO2 nanocomposite coatings for surfaces, dental and orthopaedic implants. Chem. Eng. J. 2021, 416, 129071. [Google Scholar] [CrossRef] [PubMed]
- Luo, D.; Zhang, H.-Q.; Xuanyuan, X.-Y.; Deng, D.; Lu, Z.-M.; Liu, W.-S.; Li, M. MXene-Derived Multifunctional Biomaterials: New Opportunities for Wound Healing. Biomater. Res. 2025, 29, 0143. [Google Scholar] [CrossRef] [PubMed]
- Bhardwaj, S.K.; Singh, H.; Khatri, M.; Kim, K.-H.; Bhardwaj, N. Advances in MXenes-based optical biosensors: A review. Biosens. Bioelectron. 2022, 202, 113995. [Google Scholar] [CrossRef] [PubMed]
- Liao, M.; Cui, Q.; Hu, Y.; Xing, J.; Wu, D.; Zheng, S.; Zhao, Y.; Yu, Y.; Sun, J.; Chai, R. Recent advances in the application of MXenes for neural tissue engineering and regeneration. Neural Regen. Res. 2024, 19, 258–263. [Google Scholar] [CrossRef] [PubMed]
- Chen, H.; Wang, Y.; Chen, X.; Wang, Z.; Wu, Y.; Dai, Q.; Zhao, W.; Wei, T.; Yang, Q.; Huang, B.; et al. Research Progress on Ti3C2Tx-Based Composite Materials in Antibacterial Field. Molecules 2024, 29, 2902. [Google Scholar] [CrossRef] [PubMed]
- Zhang, J.; Fu, Y.; Mo, A. Multilayered Titanium Carbide MXene Film for Guided Bone Regeneration. Int. J. Nanomed. 2019, 14, 10091–10103. [Google Scholar] [CrossRef] [PubMed]
- Li, J.; Fan, Z.; Guan, Z.; Ruan, J. Injectable MXene/Ag-HA composite hydrogel for enhanced alveolar bone healing and mechanistic study. Front. Bioeng. Biotechnol. 2024, 12, 1485437. [Google Scholar] [CrossRef] [PubMed]
- Zhu, Y.; Liu, H.; Wu, P.; Chen, Y.; Deng, Z.; Cai, L.; Wu, M. Multifunctional injectable hydrogel system as a mild photothermal-assisted therapeutic platform for programmed regulation of inflammation and osteo-microenvironment for enhanced healing of diabetic bone defects in situ. Theranostics 2024, 14, 7140–7198. [Google Scholar] [CrossRef] [PubMed]
- Wirsig, K.; Kilian, D.; von Witzleben, M.; Gelinsky, M.; Bernhardt, A. Impact of Sr2+ and hypoxia on 3D triple cultures of primary human osteoblasts, osteocytes and osteoclasts. Eur. J. Cell Biol. 2022, 101, 151256. [Google Scholar] [CrossRef] [PubMed]
- Li, Y.; Qi, Y.; Gao, Q.; Niu, Q.; Shen, M.; Fu, Q.; Hu, K.; Kong, L. Effects of a micro/nano rough strontium-loaded surface on osseointegration. Int. J. Nanomed. 2015, 10, 4549–4563. [Google Scholar]
- Wang, H.; Ma, Y.; Li, J.; Zhou, C.; Xu, A.; Xu, Y.; He, F. Modulating autophagy by strontium-doped micro/nano rough titanium surface for promotion of osteogenesis and inhibition of osteoclastogenesis. Colloids Surf. B Biointerfaces 2022, 210, 112246. [Google Scholar] [CrossRef] [PubMed]
- Zhang, Y.; Zhu, Y.; Lu, D.; Dong, W.; Bi, W.; Feng, X.; Wen, L.; Sun, H.; Qi, M. Evaluation of osteogenic and antibacterial properties of strontium/silver-containing porous TiO2 coatings prepared by micro-arc oxidation. J. Biomed. Mater. Res. B Appl. Biomater. 2021, 109, 505–516. [Google Scholar] [CrossRef] [PubMed]
- Abdalla, M.M.; Sayed, O.; Lung, C.Y.K.; Rajasekar, V.; Yiu, C.K.Y. Applications of Bioactive Strontium Compounds in Dentistry. J. Funct. Biomater. 2024, 15, 216. [Google Scholar] [CrossRef] [PubMed]
- Pan, C.; Liu, T.; Yang, Y.; Liu, T.; Gong, Z.; Wei, Y.; Quan, L.; Yang, Z.; Liu, S. Incorporation of Sr2+ and Ag nanoparticles into TiO2 nanotubes to synergistically enhance osteogenic and antibacterial activities for bone repair. Mater. Des. 2020, 196, 109086. [Google Scholar] [CrossRef]
- Jang, J.H.; Oh, J.S.; Lee, E.J.; Han, C.M. Electophoretically Deposition of Ti3C2 on Titanium Surface for Hard Tissue Implant Applications. Coatings 2021, 11, 761. [Google Scholar] [CrossRef]
- Jin, G.; Cao, H.; Qiao, Y.; Meng, F.; Zhu, H.; Liu, X. Osteogenic activity and antibacterial effect of zinc ion implanted titanium. Colloids Surf. B Biointerfaces 2014, 117, 158–165. [Google Scholar] [CrossRef] [PubMed]
- Allen-Perry, K.; Straka, W.; Keith, D.; Han, S.; Reynolds, L.; Gautam, B.; Autrey, D.E. Tuning the Magnetic Properties of Two-Dimensional MXenes by Chemical Etching. Materials 2021, 14, 694. [Google Scholar] [CrossRef] [PubMed]
- Xie, X.; Zhu, Y.; Li, F.; Zhou, X.; Xue, T. Preparation and characterization of Ti3C2Tx with SERS properties. Sci. China Technol. Sci. 2019, 62, 1202–1209. [Google Scholar] [CrossRef]
- Zhang, Y.; Liu, L.; Li, M.; Wang, S.; Fu, J.; Yang, M.; Yan, C.; Liu, Y.; Zheng, Y. Dose-dependent enhancement of in vitro osteogenic activity on strontium-decorated polyetheretherketone. Sci. Rep. 2025, 15, 3063. [Google Scholar] [CrossRef] [PubMed]
- Zhang, P.; Cao, J.; Yang, Z.; Wu, Z.; Wu, L. Adsorptive Removal of Sr (Ii) by Means of Multilayer Titanium Carbon Nitrogen (Ti3cntx) Mxene: Box-Behnken Modeling Design and Experimental Study. SSRN 2022. [Google Scholar] [CrossRef]
- Barberi, J.; Spriano, S. Titanium and Protein Adsorption: An Overview of Mechanisms and Effects of Surface Features. Materials 2021, 14, 1590. [Google Scholar] [CrossRef] [PubMed]
- Shao, H.; Ma, M.; Wang, Q.; Yan, T.; Zhao, B.; Guo, S.; Tong, S. Advances in the superhydrophilicity-modified titanium surfaces with antibacterial and pro-osteogenesis properties: A review. Front. Bioeng. Biotechnol. 2022, 10, 1000401. [Google Scholar] [CrossRef] [PubMed]
- Taloub, N.; Henniche, A.; Liu, L.; Li, J.; Rahoui, N.; Hegazy, M.; Huang, Y. Improving the mechanical properties, UV and hydrothermal aging resistance of PIPD fiber using MXene (Ti3C2(OH)2) nanosheets. Compos. Part B Eng. 2019, 163, 260–271. [Google Scholar] [CrossRef]
- Huang, S.; Fu, Y.; Mo, A. Electrophoretic-deposited MXene titanium coatings in regulating bacteria and cell response for peri-implantitis. Front. Chem. 2022, 10, 991481. [Google Scholar] [CrossRef] [PubMed]
- Qiu, K.; Zhang, Y.; Wang, L.; Wu, M.; Jin, J.; Shi, W. N-Functionalized Ti2C MXene as a High-Performance Adsorbent for Strontium Ions: A First-Principles Study. J. Phys. Chem. C 2023, 127, 11167–11175. [Google Scholar] [CrossRef]
- Su, T.-R.; Huang, T.-H.; Kao, C.-T.; Ng, H.Y.; Chiu, Y.-C.; Hsu, T.-T. The Calcium Channel Affect Osteogenic Differentiation of Mesenchymal Stem Cells on Strontium-Substituted Calcium Silicate/Poly-ε-Caprolactone Scaffold. Processes 2020, 8, 198. [Google Scholar] [CrossRef]
- Qiao, L.; Zheng, X.; Xie, C.; Wang, Y.; Ye, L.; Zhao, J.; Liu, J. Bioactive Materials in Vital Pulp Therapy: Promoting Dental Pulp Repair Through Inflammation Modulation. Biomolecules 2025, 15, 258. [Google Scholar] [CrossRef] [PubMed]
- Rozmysłowska-Wojciechowska, A.; Mitrzak, J.; Szuplewska, A.; Chudy, M.; Woźniak, J.; Petrus, M.; Wojciechowski, T.; Vasilchenko, A.S.; Jastrzębska, A.M. Engineering of 2D Ti3C2 MXene Surface Charge and its Influence on Biological Properties. Materials 2020, 13, 2347. [Google Scholar] [CrossRef] [PubMed]
- Wychowaniec, J.K.; Litowczenko, J.; Tadyszak, K.; Natu, V.; Aparicio, C.; Peplińska, B.; Barsoum, M.W.; Otyepka, M.; Scheibe, B. Unique cellular network formation guided by heterostructures based on reduced graphene oxide—Ti3C2Tx MXene hydrogels. Acta Biomater. 2020, 115, 104–115. [Google Scholar] [CrossRef] [PubMed]
- Liu, X.; Huang, H.; Zhang, J.; Sun, T.; Zhang, W.; Li, Z. Recent Advance of Strontium Functionalized in Biomaterials for Bone Regeneration. Bioengineering 2023, 10, 414. [Google Scholar] [CrossRef] [PubMed]
- Liu, Z.; Yu, Z.; Chang, H.; Wang, Y.; Xiang, H.; Zhang, X.; Yu, B. Strontium-containing α-calcium sulfate hemihydrate promotes bone repair via the TGF-β/Smad signaling pathway. Mol. Med. Rep. 2019, 20, 3555–3564. [Google Scholar] [CrossRef] [PubMed]
- Yang, F.; Yang, D.; Tu, J.; Zheng, Q.; Cai, L.; Wang, L. Strontium enhances osteogenic differentiation of mesenchymal stem cells and in vivo bone formation by activating Wnt/catenin signaling. Stem Cells 2011, 29, 981–991. [Google Scholar] [CrossRef] [PubMed]
- Yu, H.; Liu, Y.; Yang, X.; He, J.; Zhong, Q.; Guo, X. The anti-inflammation effect of strontium ranelate on rat chondrocytes with or without IL-1β in vitro. Exp. Ther. Med. 2022, 23, 208. [Google Scholar] [CrossRef] [PubMed]
- Rybchyn, M.S.; Slater, M.; Conigrave, A.D.; Mason, R.S. An Akt-dependent increase in canonical Wnt signaling and a decrease in sclerostin protein levels are involved in strontium ranelate-induced osteogenic effects in human osteoblasts. J. Biol. Chem. 2011, 286, 23771–23779. [Google Scholar] [CrossRef] [PubMed]
- Alves Côrtes, J.; Dornelas, J.; Duarte, F.; Messora, M.R.; Mourão, C.F.; Alves, G. The Effects of the Addition of Strontium on the Biological Response to Calcium Phosphate Biomaterials: A Systematic Review. Appl. Sci. 2024, 14, 7566. [Google Scholar] [CrossRef]
- Geng, T.; Wang, Y.; Lin, K.; Zhang, C.; Wang, J.; Liu, Y.; Yuan, C.; Wang, P. Strontium-doping promotes bone bonding of titanium implants in osteoporotic microenvironment. Front. Bioeng. Biotechnol. 2022, 10, 1011482. [Google Scholar] [CrossRef] [PubMed]
- Xing, H.; Li, R.; Wei, Y.; Ying, B.; Li, D.; Qin, Y. Improved Osteogenesis of Selective-Laser-Melted Titanium Alloy by Coating Strontium-Doped Phosphate with High-Efficiency Air-Plasma Treatment. Front. Bioeng. Biotechnol. 2020, 8, 367. [Google Scholar] [CrossRef] [PubMed]
- Wang, H.; Hsu, Y.C.; Wang, C.; Xiao, X.; Yuan, Z.; Zhu, Y.; Yang, D. Conductive and Enhanced Mechanical Strength of Mo2Ti2C3 MXene-Based Hydrogel Promotes Neurogenesis and Bone Regeneration in Bone Defect Repair. ACS Appl. Mater. Interfaces 2024, 16, 17208–17218. [Google Scholar] [CrossRef] [PubMed]
- Kermani, F.; Mollazadeh Beidokhti, S.; Baino, F.; Gholamzadeh-Virany, Z.; Mozafari, M.; Kargozar, S. Strontium- and Cobalt-Doped Multicomponent Mesoporous Bioactive Glasses (MBGs) for Potential Use in Bone Tissue Engineering Applications. Materials 2020, 13, 1348. [Google Scholar] [CrossRef] [PubMed]
- Martín-del-Campo, M.; Sampedro, J.G.; Flores-Cedillo, M.L.; Rosales-Ibañez, R.; Rojo, L. Bone Regeneration Induced by Strontium Folate Loaded Biohybrid Scaffolds. Molecules 2019, 24, 1660. [Google Scholar] [CrossRef] [PubMed]
- Nie, R.; Sun, Y.; Lv, H.; Lu, M.; Huangfu, H.; Li, Y.; Zhang, Y.; Wang, D.; Wang, L.; Zhou, Y. 3D printing of MXene composite hydrogel scaffolds for photothermal antibacterial activity and bone regeneration in infected bone defect models. Nanoscale 2022, 14, 8112–8129. [Google Scholar] [CrossRef] [PubMed]
- Bizelli-Silveira, C.; Abildtrup, L.A.; Spin-Neto, R.; Foss, M.; Søballe, K.; Kraft, D.C.E. Strontium enhances proliferation and osteogenic behavior of bone marrow stromal cells of mesenchymal and ectomesenchymal origins in vitro. Clin. Exp. Dent. Res. 2019, 5, 541–550. [Google Scholar] [CrossRef] [PubMed]
- Jang, J.-H.; Lee, E.-J. Influence of MXene Particles with a Stacked-Lamellar Structure on Osteogenic Differentiation of Human Mesenchymal Stem Cells. Materials 2021, 14, 4453. [Google Scholar] [CrossRef] [PubMed]
- Wang, L.; Jiang, S.; Zhou, J.; Gholipourmalekabadi, M.; Cao, Y.; Lin, K.; Zhuang, Y.; Yuan, C. From hard tissues to beyond: Progress and challenges of strontium-containing biomaterials in regenerative medicine applications. Bioact. Mater. 2025, 49, 85–120. [Google Scholar] [CrossRef] [PubMed]
- Zhang, J.; Tang, S.; Ding, N.; Ma, P.; Zhang, Z. Surface-modified Ti3C2 MXene nanosheets for mesenchymal stem cell osteogenic differentiation via photothermal conversion. Nanoscale Adv. 2023, 5, 2921–2932. [Google Scholar] [CrossRef] [PubMed]
- Sun, T.; Ma, D.; Song, Y.; Hu, J.; Yang, Z.; Wang, X.; Zhang, J. Effects of 0.01 mM strontium on human periodontal ligament stem cell osteogenic differentiation via the Wnt/β-catenin signaling pathway. J. Int. Med. Res. 2025, 53, 3000605251315024. [Google Scholar] [CrossRef] [PubMed]
- Yang, J.; Bao, W.; Jaumaux, P.; Zhang, S.; Wang, C.; Wang, G. MXene-based composites: Synthesis and applications in rechargeable batteries and supercapacitors. Adv. Mater. Interfaces 2019, 6, 1802004. [Google Scholar] [CrossRef]
- Rauch, C.; Leigh, J. Theoretical evaluation of wall teichoic acids in the cavitation-mediated pores formation in Gram-positive bacteria subjected to an electric field. Biochim. Et Biophys. Acta (BBA) Gen. Subj. 2015, 1850, 595–601. [Google Scholar] [CrossRef] [PubMed]
- Alimohammadi, F.; Sharifian Gh, M.; Attanayake, N.H.; Thenuwara, A.C.; Gogotsi, Y.; Anasori, B.; Strongin, D.R. Antimicrobial Properties of 2D MnO(2) and MoS(2) Nanomaterials Vertically Aligned on Graphene Materials and Ti(3)C(2) MXene. Langmuir 2018, 34, 7192–7200. [Google Scholar] [CrossRef] [PubMed]
- Ou, L.; Song, B.; Liang, H.; Liu, J.; Feng, X.; Deng, B.; Sun, T.; Shao, L. Toxicity of graphene-family nanoparticles: A general review of the origins and mechanisms. Part. Fibre Toxicol. 2016, 13, 57. [Google Scholar] [CrossRef] [PubMed]
- Santos, X.; Álvarez, M.; Videira-Quintela, D.; Mediero, A.; Rodríguez, J.; Guillén, F.; Pozuelo, J.; Martín, O. Antibacterial Capability of MXene (Ti3C2Tx) to Produce PLA Active Contact Surfaces for Food Packaging Applications. Membranes 2022, 12, 1146. [Google Scholar] [CrossRef] [PubMed]
- Rasool, K.; Helal, M.; Ali, A.; Ren, C.E.; Gogotsi, Y.; Mahmoud, K.A. Antibacterial Activity of Ti3C2Tx MXene. ACS Nano 2016, 10, 3674–3684. [Google Scholar] [CrossRef] [PubMed]
- Rasool, K.; Mahmoud, K.A.; Johnson, D.J.; Helal, M.; Berdiyorov, G.R.; Gogotsi, Y. Efficient Antibacterial Membrane Based on Two-Dimensional Ti3C2Tx (MXene) Nanosheets. Sci. Rep. 2017, 7, 1598. [Google Scholar] [CrossRef] [PubMed]
- Wu, D.; Zhao, R.; Chen, Y.; Wang, Y.; Li, J.; Fan, Y. Molecular insights into MXene destructing the cell membrane as a “nano thermal blade”. Phys. Chem. Chem. Phys. 2021, 23, 3341–3350. [Google Scholar] [CrossRef] [PubMed]
- Rajavel, K.; Shen, S.; Ke, T.; Lin, D. Achieving high bactericidal and antibiofouling activities of 2D titanium carbide (Ti3C2Tx) by delamination and intercalation. 2D Mater. 2019, 6, 035040. [Google Scholar] [CrossRef]
- Ye, S.; Zhang, H.; Lai, H.; Xu, J.; Yu, L.; Ye, Z.; Yang, L. MXene: A wonderful nanomaterial in antibacterial. Front. Bioeng. Biotechnol. 2024, 12, 1338539. [Google Scholar] [CrossRef] [PubMed]
- Alshammari, H.; Bakitian, F.; Neilands, J.; Andersen, O.Z.; Stavropoulos, A. Antimicrobial Properties of Strontium Functionalized Titanium Surfaces for Oral Applications, A Systematic Review. Coatings 2021, 11, 810. [Google Scholar] [CrossRef]

Disclaimer/Publisher’s Note: The statements, opinions and data contained in all publications are solely those of the individual author(s) and contributor(s) and not of MDPI and/or the editor(s). MDPI and/or the editor(s) disclaim responsibility for any injury to people or property resulting from any ideas, methods, instructions or products referred to in the content. |
© 2025 by the authors. Licensee MDPI, Basel, Switzerland. This article is an open access article distributed under the terms and conditions of the Creative Commons Attribution (CC BY) license (https://creativecommons.org/licenses/by/4.0/).
Share and Cite
Lai, Y.; Mo, A. Strontium-Doped Ti3C2Tx MXene Coatings on Titanium Surfaces: Synergistic Osteogenesis Enhancement and Antibacterial Activity Evaluation. Coatings 2025, 15, 847. https://doi.org/10.3390/coatings15070847
Lai Y, Mo A. Strontium-Doped Ti3C2Tx MXene Coatings on Titanium Surfaces: Synergistic Osteogenesis Enhancement and Antibacterial Activity Evaluation. Coatings. 2025; 15(7):847. https://doi.org/10.3390/coatings15070847
Chicago/Turabian StyleLai, Yancheng, and Anchun Mo. 2025. "Strontium-Doped Ti3C2Tx MXene Coatings on Titanium Surfaces: Synergistic Osteogenesis Enhancement and Antibacterial Activity Evaluation" Coatings 15, no. 7: 847. https://doi.org/10.3390/coatings15070847
APA StyleLai, Y., & Mo, A. (2025). Strontium-Doped Ti3C2Tx MXene Coatings on Titanium Surfaces: Synergistic Osteogenesis Enhancement and Antibacterial Activity Evaluation. Coatings, 15(7), 847. https://doi.org/10.3390/coatings15070847
